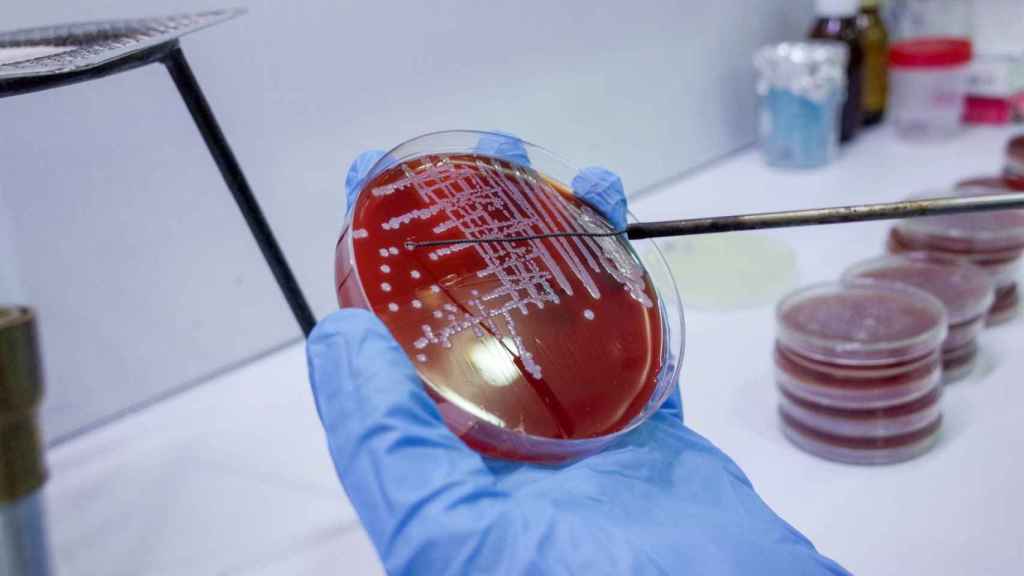
Crecimiento bacteriano.

Crecimiento bacteriano.
Ofrecido por:
Siete afectados por el brote de legionela en A Guarda y O Rosal reciben el alta médica
El origen del brote está siendo investigado, por lo que no se puede concluir, por el momento, cuál es la fuente de exposición
La Consellería de Sanidade ha informado de que siete personas afectadas por el brote de legionela en A Guarda y O Rosal, en el sur de la provincia de Pontevedra, han sido dadas de alta, y que otras tres permanecen ingresadas, dos en planta y una en UCI.
La Dirección Xeral de Saúde Pública da Consellería de Sanidade sigue investigando el origen del brote. Por el momento, todavía no se puede concluir cuál es la fuente de exposición.
La legionelosis es una neumonía grave causada por la bacteria Legionella, que se encuentra en ambientes de agua dulce, como lagos y arroyos. Entre los síntomas más comunes de la enfermedad se encuentran fiebre, dolores musculares, pérdida de apetito, cefalea y malestar general.



